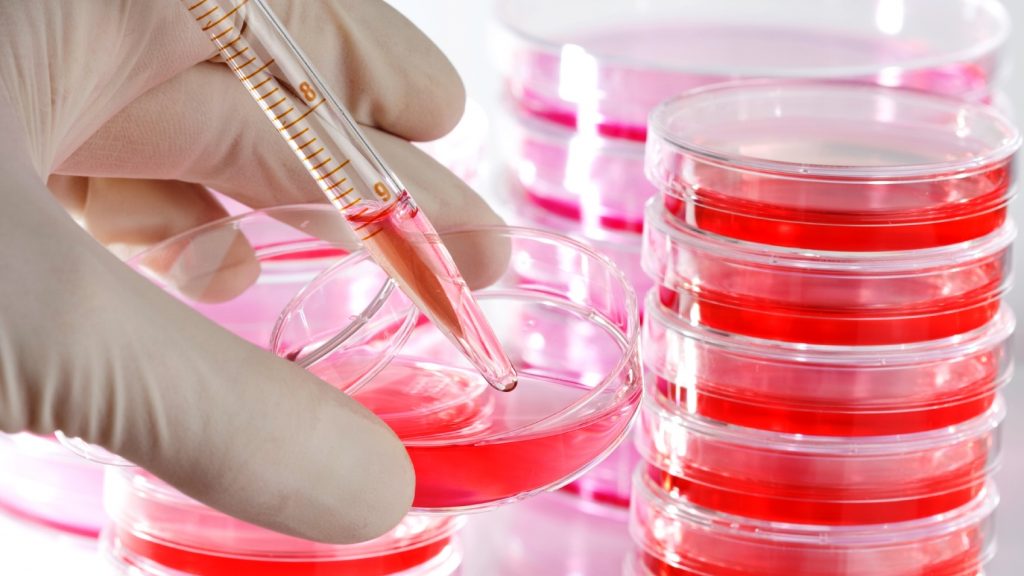

Studi neuroscientifici in merito alla dipendenza affettiva (DA) effettuati da ricercatori in campo neurobiologico, offrono un importante spunto utile all’ottimizzazione dell’approccio psicoterapeutico da parte di professionisti a stretto contatto con soggetti vittime di abuso narcisistico. Questo scritto funge da guida, dal punto di vista psicobiologico, ed espone i pattern e le dinamiche che si innescano … Continua a leggere Ruolo della Neurobiologia nella Dipendenza Affettiva: Implicazioni Terapeutiche e Psicobiologiche
Articoli
Anemie emolitiche: sintomatologia, diagnosi e cura
L'anemia è una condizione in cui il numero di globuli rossi non è sufficiente a trasportare abbastanza ossigeno da soddisfare i bisogni dei diversi tessuti e organi del corpo. Esistono numerose forme di anemia, ciascuna causata da fattori diversi. Una di esse è l’anemia emolitica, caratterizzata da emolisi, ovvero un’eccessiva distruzione dei globuli rossi, importanti cellule del sangue adibite al trasporto dell'ossigeno
Patologie renali: pielonefrite acuta
La pielonefrite acuta è una patologia infiammatoria, causata da un’infezione batterica che coinvolge principalmente il tessuto parenchimale renale. L’infiammazione si estende lungo tutto il tratto urinario (UTI), coinvolgendo, oltre ai reni, l’uretra e la vescica. I principali sintomi che evidenziano l’insorgere della patologia sono: poliuria, febbre, dolori pelvici, nausea e vomito.
Le colture cellulari: modelli sperimentali nella ricerca biomedica
I metodi biologici si dividono in due differenti tipologie: in vivo e in vitro. I metodi biologici in vivo consistono nell’uso di organismi viventi nella loro integrità, per esempio gli esperimenti sugli animali da laboratorio. In vitro, invece, riguardano fenomeni biologici riguardanti lo studio dell'interazione tra le cellule di un organo di interesse, solitamente coltivate in contenitori detti plate o flask. … Continua a leggere Le colture cellulari: modelli sperimentali nella ricerca biomedica
Cellule staminali: applicazioni terapeutiche e ricerca biomedica
Le cellule staminali sono cellule primitive che possiedono la capacità di trasformarsi in circa 200 tipi cellulari diversi. Vengono attualmente utilizzate come terapia medica nei confronti di diverse patologie.
Il colore degli occhi e genetica dell’occhio azzurro
Il colore degli occhi definisce un importante tratto poligenico che contraddistingue, insieme ad altre numerose caratteristiche estetiche, l'aspetto esteriore, ossia il fenotipo, di un individuo. Vediamo insieme quali sono i geni che stabiliscono le diverse colorazioni e qual è stata la principale mutazione che ha portato alla formazione degli occhi azzurri.
Intervista al dott. Roberto Boffi: i danni ai polmoni causati dal fumo e dallo smog
Intervista al prof. Roberto Boffi,responsabile del Dipartimento di Pneumologia dell’Istituto Nazionale dei Tumori: i danni del fumo e dello smog.
Vaccini: composizione, meccanismo d’azione e controllo
Il vaccino è considerato una delle più grandi scoperte mediche fatte dall’uomo, rappresentando, un importante ed efficace strumento di prevenzione della sanità pubblica che consente di evitare la diffusione di malattie anche gravi, persino mortali. Grazie alle vaccinazioni è stato possibile debellare patologie un tempo molto diffuse o, comunque, a ridurne in maniera drastica l'incidenza.
Desossiribovirus e Ribovirus: caratteristiche ed esempi
I virus possono presentarsi con un genoma a DNA, detti desossiribovirus, e a RNA, chiamati ribovirus. Vediamo insieme le caratteristiche peculiari che li differenziano l'uno dall'altro e degli esempi utili per comprendere al meglio i meccanismi di replicazione e adattamento.
Il pancreas: anatomia, fisiologia e patologia
Come tutti gli organi, anche il pancreas può andare incontro ad infiammazioni acute o croniche che prendono il nome di pancreatiti. La dieta risulta essere la principale priorità su cui concentrarsi per prevenire processi infiammatori dell'organo o per favorire la guarigione dello stesso.